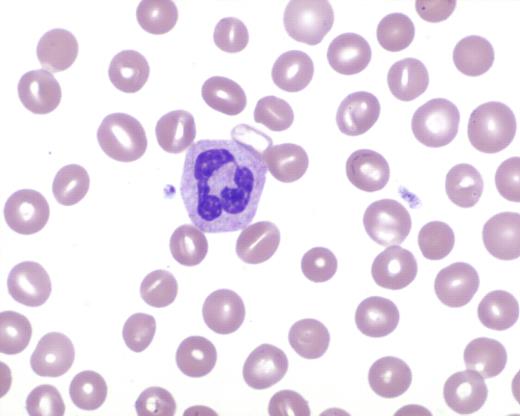

Abstract
Abstract 5090
The evaluation of a patient with new onset hemolytic anemia is among the more common clinical scenarios prompting formal input by a hematologist. Although there are both common and uncommon etiologies, the presentation of Wilson's Disease, itself an uncommon disorder, as a fulminant hemolytic anemia, is very uncommon, and for this reason may not be readily considered within the differential diagnosis of new onset hemolytic anemia. Wilson's Disease occurs worldwide with an average prevalence of only 30 affected individuals per million population. In order to illustrate hemolytic anemia as an initial presentation of Wilson's Disease, a case is reported.
A 28-year-old female patient presented with a recent diarrheal infection and new onset jaundice. Examination revealed an afebrile patient with gross jaundice, but no other abnormal findings. Initial significant laboratory findings included a hemoglobin of 7.1 gm/dL, white blood cell count of 30,900 per microliter, platelet count of 181,000 per microliter, creatinine of 2 mg/dL, and total bilirubin of approximately 10 mg/dL. Within two days, laboratory studies worsened to a serum creatinine of 3.5 mg/dL, total bilirubin 19.5 mg/dL, direct bilirubin 13.1 mg/dL, AST 130 IU/L, ALT 16 IU/L, and alkaline phosphatase < 5 IU/L. The serum LDH was markedly elevated at 1258 IU/L. Review of the peripheral blood film showed 87% segmented neutrophils with no schistocytosis. However, a striking stomatocytosis was present, comprising about 20% of the red blood cells (see Figure 1). In the next two days, the clinical condition dramatically worsened. The hemoglobin dropped to 4.4 gm/dL, and the prothrombin time increased from within normal limits to 52.7 seconds. Disseminated intravascular coagulation was not present. Haptoglobin and LDH remained consistent with a brisk intravascular hemolysis, and Coombs testing was negative. In addition, the total bilirubin rose to 52.5 mg/dL, with a direct bilirubin of 38.7 mg/dL. The patient's sensorium was becoming gradually impaired, consistent with a hepatic encephalopathy. Based on this constellation of findings, the possibility of a fulminant manifestation of Wilson's Disease, featuring severe hemolysis, was identified (see Table 1). This led to definitive testing for Wilson's Disease, which included a liver biopsy with qualitative and quantitative measurements for copper (copper dry weight = 966.7 micrograms/gm). With the diagnosis established, and using support from published literature, daily plasmapheresis was utilized to stabilize the patient in anticipation of orthotopic liver transplantation (Jhang JS et al. Journal of Clinical Apheresis 22(1):10-14, 2007). Subsequently, the patient was successfully transplanted, and continues to do well three months afterwards.
High power field of a peripheral smear photomicrograph exhibiting stomatocytosis.
High power field of a peripheral smear photomicrograph exhibiting stomatocytosis.
Clinical manifestations classically described with the syndrome of acute Wilsonian crisis. (An X et al. British Journal of Haematology 141: 367-375, 2008)
| Clinical Features of Acute Wilsonian Crisis . | |
|---|---|
| 1 | Coombs-negative hemolytic anemia with features of acute intravascular hemolysis |
| 2 | Coagulopathy unresponsive to parenteral vitamin K administration |
| 3 | Rapid progression to renal failure |
| 4 | Relatively modest rises in serum aminotransferases (typically < 2,000 IU/L) from the beginning of clinical illness |
| 5 | Normal or markedly subnormal serum alkaline phosphatase (typically < 40 IU/L) |
| 6 | Female to male ratio of 2:1 |
| Clinical Features of Acute Wilsonian Crisis . | |
|---|---|
| 1 | Coombs-negative hemolytic anemia with features of acute intravascular hemolysis |
| 2 | Coagulopathy unresponsive to parenteral vitamin K administration |
| 3 | Rapid progression to renal failure |
| 4 | Relatively modest rises in serum aminotransferases (typically < 2,000 IU/L) from the beginning of clinical illness |
| 5 | Normal or markedly subnormal serum alkaline phosphatase (typically < 40 IU/L) |
| 6 | Female to male ratio of 2:1 |
The present case highlights the value of understanding the possible etiologies of stomatocytosis, as observed in the peripheral smear, in the setting of a hemolytic anemia (see Table 2). In addition, as illustrated by this case, plasmapheresis can be an effective bridge to stabilize patients for liver transplantation in patients with Wilson's Disease who present with fulminant hemolytic anemia.
Differential diagnosis of spherocytosis in the peripheral blood smear. (Hogland HC et al. Mayo Clinic Proceedings 53(8): 498-500, 1978)
| Etiologies of Peripheral Blood Stomatocytosis . |
|---|
| Preparation Artifact |
| Severe Liver Disease |
| Acute Alcohol Ingestion |
| Severe Cardiac Failure |
| Chemotherapy Toxicity |
| Hereditary, including Rh null syndrome |
| Etiologies of Peripheral Blood Stomatocytosis . |
|---|
| Preparation Artifact |
| Severe Liver Disease |
| Acute Alcohol Ingestion |
| Severe Cardiac Failure |
| Chemotherapy Toxicity |
| Hereditary, including Rh null syndrome |
No relevant conflicts of interest to declare.
Author notes
Asterisk with author names denotes non-ASH members.
This feature is available to Subscribers Only
Sign In or Create an Account Close Modal